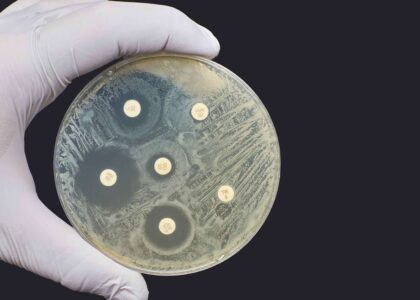

Antibiotic Susceptibility Testing Market Surpasses US$ 4.05 Billion in Revenue by 2028
The global antibiotic susceptibility testing market generated US$2.82 billion in revenue in 2021. By 2028,

The global antibiotic susceptibility testing market generated US$2.82 billion in revenue in 2021. By 2028,

According to recently published data from Future Industry Insights’ analysis of the silk protein market, the

The United Kingdom curtain walling market is expected to expand from US$ 2,886.5 million in

The coconut milk products market is projected to reach US$ 1.2 billion in 2022, driven by growing health
Twisted Handle Bags Market: Unveiling the Trendiest Accessories In the realm of fashion and accessories,

The global egg substitute market is expected to develop quickly, with a projected CAGR of 17.5%

The USA hunting equipment and accessories market is estimated to reach at US$ 15,573.8 million

According to the FMI analysis, oranges were used in the production of roughly 40% of

The plant-based fish feed market is valued at US$ 6.8 Billion in 2021. It is set to
Asia Pacific Sachet Packaging Machines Market is anticipated to soar between 2023 and 2033 at